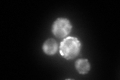
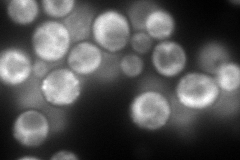
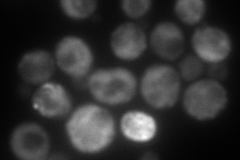
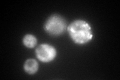
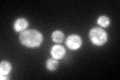

View description
Acetyl-CoA carboxylase, biotin containing enzyme that catalyzes the carboxylation of acetyl-CoA to form malonyl-CoA; required for de novo biosynthesis of long-chain fatty acids
Localization:
Intensity:
Fold change:
Significance:
-
C’ GFP library in SD
punctate, cytosol348.88 -
N' NOP1pr-GFP in SD
cytosol,punctate231.971 -
N' TEF2pr-mCherry in SD
cytosol,punctate192.195 -
N' NATIVEpr-GFP in SD

cytosol135.351 -
N' TEF2pr-VC and Cyto-VN in SD

cytosol58.8492 -
C’ GFP library in SD+DTT

punctateN/AN/ANo -
C’ GFP library in SD+H2O2
punctate, cytosol288.850.82No -
C’ GFP library in Starvation Media
punctate, cytosol216.690.62No -
C’ GFP library on the background of Pup2-DaMP

punctate -
C’ GFP library on the background of CCT mutant

punctate, cytosol303.4230.869701No
